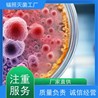

产品单价 |
6.00元/箱 |
起订量 |
1箱 |
供货总量 |
1200 箱 |
发货期限 |
自买家付款之日起2天内发货 |
品牌 |
戈瑞高能 |
产地 |
深圳 |
潮湿与霉变,是物品存储的隐形。无论是珍贵的书籍、昂贵的皮具,还是精密的电子设备,一旦遭遇霉菌侵蚀,轻则留下难看的斑痕,重则导致功能性损坏。传统防霉手段往往需要拆箱晾晒或喷洒化学药剂,既耗费人力又存在二次污染风险,而【免拆箱辐照防霉技术】的诞生,正以颠覆性创新为物品防护开辟全新路径。
这项技术依托高能电子束辐照原理,能在不拆解包装的情况下穿透箱体,直接灭杀霉菌孢子与微生物。实验数据显示,经过辐照处理的物品防霉有效期长达12个月以上,灭菌率高达99.9%,且全程不添加任何化学物质,规避了传统防霉剂可能导致的变色、腐蚀问题。对于仓储物流企业而言,成吨的货物只需通过辐照通道即可完成整体防护,单日处理量可达数百立方米;家庭用户则可通过服务商对贵重物品进行定向处理,尤其适合字画、古董等不可逆损物品的长久保存。
更令人安心的是,辐照防霉已通过国际安全认证,处理后的物品无辐射残留,食品、药品、母婴用品等敏感品类均可放心使用。在梅雨季节频发的南方地区,这项技术已帮助数千家企业挽回因霉变造成的经济损失,某家具品牌更借此将产品保质期延长了3倍,赢得海外客户广泛好评。
 守护物品本质就是守护价值。选择免拆箱辐照防霉,不仅是选择一种便捷的防霉方式,更是为珍贵物品构建起无形的科技屏障。无需等待霉斑显现才追悔莫及,主动防御才是现代人对抗自然侵蚀的智慧之选。立即体验,让防霉技术成为您安心存储的底气,从此告别"开箱惊变"的烦恼。
守护物品本质就是守护价值。选择免拆箱辐照防霉,不仅是选择一种便捷的防霉方式,更是为珍贵物品构建起无形的科技屏障。无需等待霉斑显现才追悔莫及,主动防御才是现代人对抗自然侵蚀的智慧之选。立即体验,让防霉技术成为您安心存储的底气,从此告别"开箱惊变"的烦恼。
| 深圳市戈瑞辐照科技有限公司 | |||
|---|---|---|---|
| 联系人 | 陈经理 |
微信 | 18675512707 |
| 手机 | ����������� | 邮箱 | 961881236@qq.com |
| 传真 | 0755-33699831 | 地址 | 公明振兴路33号第4栋 |
| 主营产品 | 辐照灭菌,深圳辐照,电子束灭菌,钴源辐照灭菌 | 网址 | /qiye2119660/ |